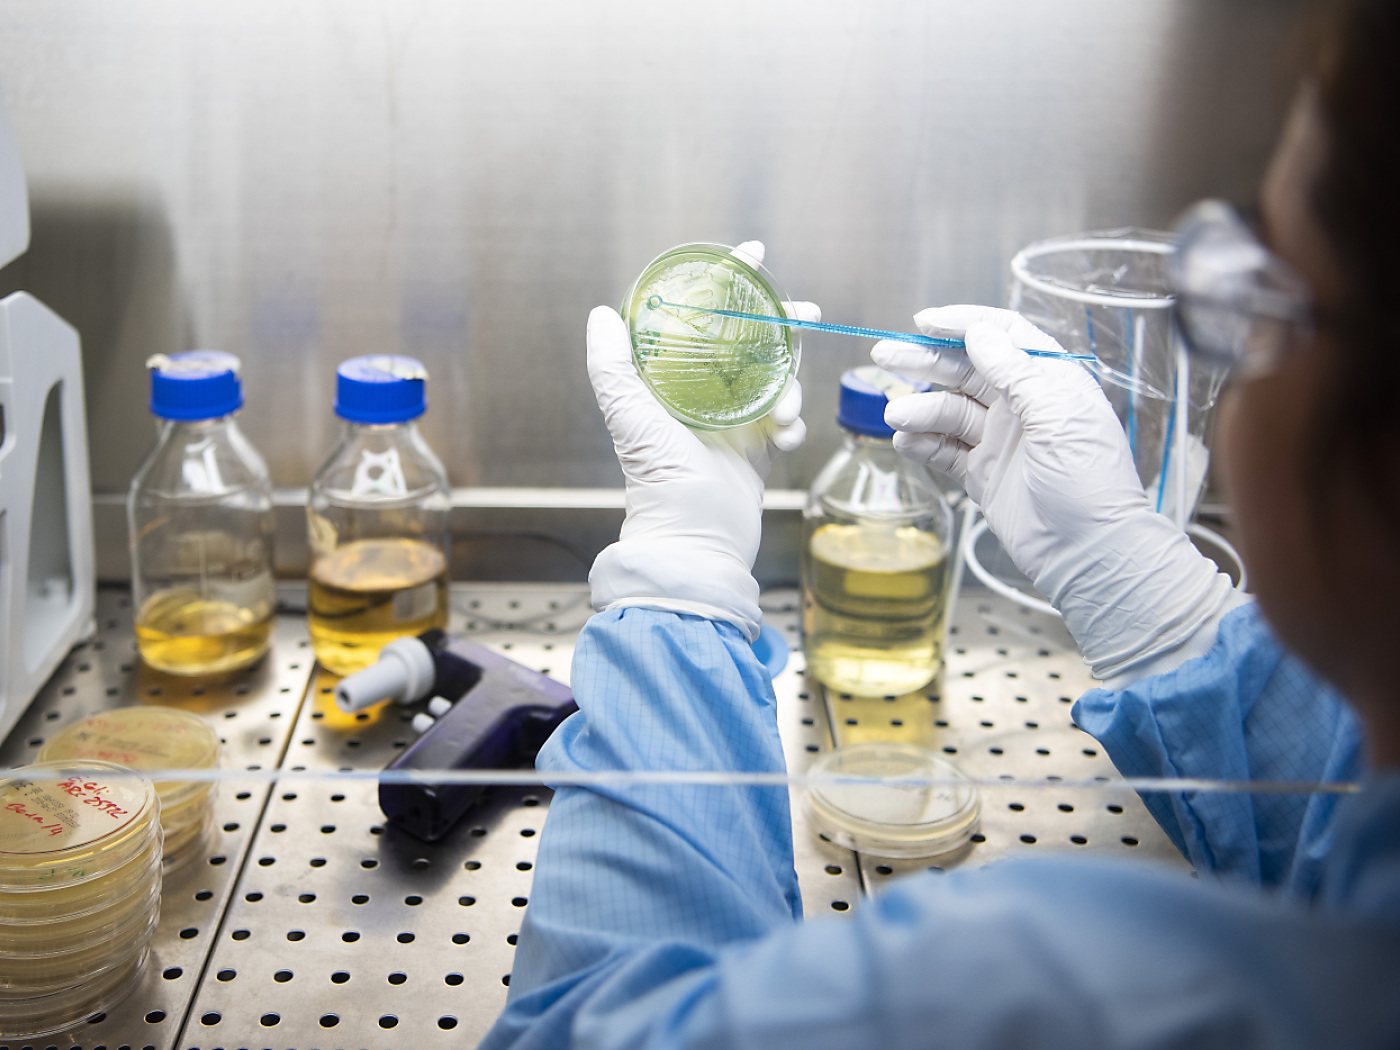

Ricerca e sviluppo, imprese investono 18 miliardi all’anno
Nel 2023 le imprese private hanno destinato 18 miliardi di franchi alle loro attività di ricerca e sviluppo (R+S) in Svizzera, con un aumento medio annuo del 3,5% dal 2021, momento dell'ultima rilevazione.
(Keystone-ATS) Stando alle indicazioni odierne dell’Ufficio federale di statistica (UST) la parte del leone è costituita dalla spesa del settore operata dall’industria farmaceutica, che mette a referto 5,5 miliardi (31% del totale). Rispetto a due anni prima la sua posizione si è però indebolita, con una flessione media del 6% all’anno. “Un calo di tali proporzioni non si era più verificato dal 2012”, sottolineano i funzionari di Neuchâtel.
La crescita del ramo della ricerca nel 2023 non è quindi stata trainata dal comparto dei medicinali, come era avvenuto in passato, bensì in particolare dai segmenti degli strumenti di alta tecnologia e dei macchinari.
Il numero di imprese che svolgono attività di R+S è stimato in poco meno di 3500. Molte realtà sono di piccole dimensioni, con meno di 50 dipendenti. Ma sono le grandi società (100 o più addetti) a essere le protagoniste in termini di risorse impegnate: esse rappresentano più di tre quarti della spesa. Fra il 2021 e il 2023 queste hanno però visto stagnare il loro impegno, mentre le ditte di medie dimensioni hanno raddoppiato le uscite nel settore e quelle piccole le hanno pure aumentate, ma non in modo così sensibile.
Le attività di ricerca realizzate dalle imprese private sono principalmente incentrate sulla salute: a tal scopo sono stati infatti stanziati 8,5 miliardi di franchi, il 47% del totale. Con un importo di quasi 6 miliardi il secondo campo nel quale si è investito di più è quello della produzione industriale e della tecnologia, con l’obiettivo di migliorare i processi produttivi. Nel 2023 il 30% delle spese di R+S, pari 5,4 miliardi di franchi, è stato stanziato per la biotecnologia: vi è stato però un calo medio annuo del 4% in confronto al 2021, la prima flessione da 2000, anno in cui è stata effettuata la prima misurazione.
L’importo speso nel 2023 dalle imprese private per l’acquisto di R+S all’estero sotto forma di mandati è aumentato notevolmente: ha infatti raggiunto i 7,9 miliardi di franchi, contro i 6,3 miliardi di franchi del 2021, un incremento che fa peraltro seguito a una contrazione durata diversi anni. Stando all’UST questo non deve essere necessariamente interpretato come una perdita di competitività da parte della comunità scientifica elvetica, poiché allo stesso tempo i fondi ricevuti dall’estero per svolgere attività di ricerca in Svizzera sono raddoppiati: tra il 2021 e il 2023 la spesa in R+S finanziata da oltre frontiera è infatti passata da 1 a 2 miliardi di franchi.
Le imprese hanno impiegato nelle attività di ricerca quasi 69’000 persone, numero in aumento annuo del 5% dal 2021. I lavoratori assunti dalle imprese private per svolgere attività di R+S sono generalmente altamente qualificati e il 45% di loro occupa una posizione di ricercatore. Il personale di ricerca è prevalentemente maschile: le donne rappresentano solo un quarto del totale, una quota stabile da diversi anni, conclude l’UST.